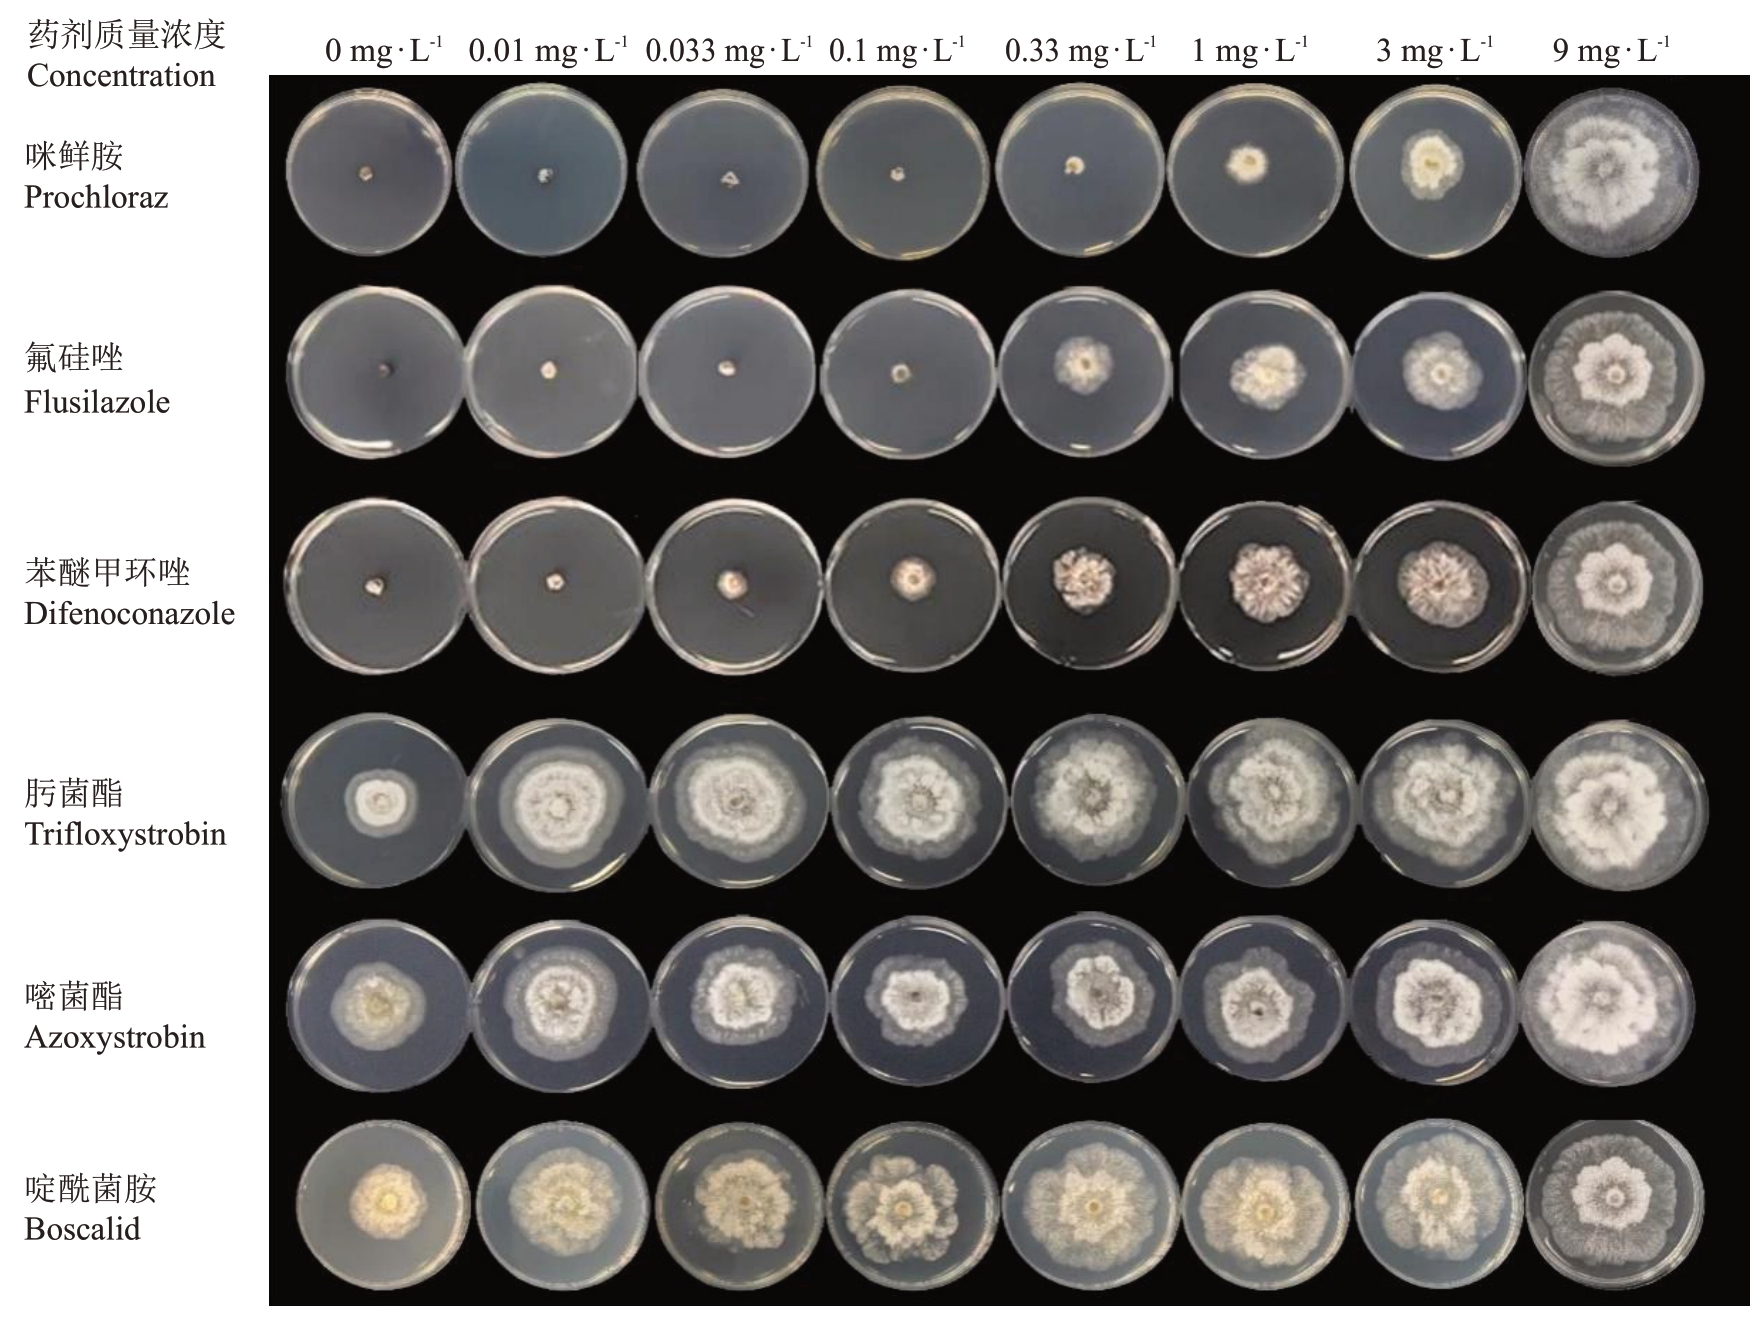

桃[Prunus persica(L.)Batsch]为蔷薇科桃属植物,起源于中国,在中国有几千年的栽培和进化历史。中国是桃生产大国,但是桃树在生长发育过程中易受多种病菌的侵染,如葡萄座腔菌(Botryosphaeria dothidea)引起的桃流胶病,桃疮痂病菌(Venturia carpophila)引起的桃疮痂病,核果链核盘菌(Monilinia laxa)引起的桃褐腐病等[1]。近年来,桃枝枯病已经成为中国南方各大桃产区最主要的真菌病害之一,发病桃树产量损失20%~50%,严重时甚至绝收,给桃农带来巨大的经济损失[2]。该病最早被外国学者于1905 年报道[3],1934 年该病在美国新泽西州首次出现,之后在美国东部沿海地区均有发生[4-5]。该病在中国的报道较晚,最早于1989年在云南地区发现[6]。该病主要危害新梢,通常在新梢基部出现褐斑,后呈环状或向上扩展,致使叶片枯黄、脱落和新枝枯死,严重影响桃树生长和果实产量,6月下旬至7 月是该病害发生的高峰期[7]。对于桃枝枯病的病原菌,Delacroix 等[3]于1905 年最早将其命名为桃壳梭孢(Fusicoccum amygdali)。Tuset 等[8]在1989 年认为发生于西班牙的桃枝枯病病原菌(F.amygdali)形态和拟茎点霉属(Phomopsis)一致,因此将桃枝枯病病原菌改名为桃拟茎点霉(Phomopsis amygdali),其有性态为间座壳属(Diaporthe)。在美国南卡罗来纳州,引起桃枝枯病的病原菌有葡萄座腔菌、桃拟茎点霉、白壳菌属以及壳囊孢属[9]。在中国桃枝枯病优势病原菌为桃拟茎点霉[6,10]。
目前,桃树枝枯病的防治主要依靠化学防治。国内外研究者对此进行了一些研究,如Uddin 等[11]研究发现,春季和秋季同时喷施杀菌剂,百菌清和克菌丹防效最佳,防效分别为46%~71%和46%~69%;其次是嘧菌酯和腈菌唑,防效分别为41%和28%~44%。纪兆林等[12]研究发现多效唑对枝枯病也有一定的防效。范昆等[13]测定了丁香菌酯、辛菌胺单剂以及不同比例的混配制剂对桃枝枯病菌的毒力和联合毒力,结果表明丁香菌酯与辛菌胺的复配对桃枝枯病菌有协同增效作用。鉴于防治桃枝枯病的药剂种类繁多,需要更多的杀菌剂筛选试验来为该病害的防控提供技术支撑。
同时,植物在生长发育过程中为了保护自身免受有害细菌、真菌和线虫的侵害,植物在进化过程中形成了通过释放挥发性物质(volatile organic compounds,VOCs)的保护机制[14]。VOCs具有直接抑菌或诱导抗性的潜力,是生物防治研究的新方向[15]。同时VOCs作为植物重要的防御体系组成部分与抗性密切相关。然而,对桃树枝枯病抗性与枝条韧皮部VOCs的关联尚不清楚。为筛选防治桃枝枯病的高效低毒化学药剂,并鉴定可能参与抗病性形成的代谢产物,笔者在本研究中通过室内毒力测定试验筛选药剂;通过韧皮部VOCs 与桃枝枯病抗性的关联分析明确正负相关VOCs;并通过接种试验进行初步验证。预期结果可为桃枝枯病的化学防治提供高效药剂选择依据,同时为基于VOCs 的生物防治新策略及抗病育种提供理论支撑。
1 材料和方法
1.1 材料
供试植物:22份桃种质的抗性详细信息见表1。
表1 22 份桃种质对桃拟茎点霉菌的抗性
Table 1 22 peach germplasms with different resistant to Phomopsis amygdali

种质Germplasms帚形山桃Zhouxingshantao红花山桃Honghuashantao白根甘肃桃Baigengansutao红根甘肃桃Honggengansutao中油蟠9号Zhongyoupan 9#中油蟠7号Zhongyoupan 7#中蟠桃13号Zhongyoupan 13#湖景蜜露Hujingmilu白花Baihua中桃红玉Zhongtaohongyu清水白桃Shimizu Hakuto奉化蟠桃Fenghua Pantao霞晖5号Xiahui 5#中蟠桃11号Zhongpantao 11#雨花露Yuhualu长岭早玉露Changling Zaoyulu奉化玉露Fenghua Yulu朝晖Zhaohui鹰嘴Yingzui日川白凤Richuan Baifeng红甘露Reddomun白凤Hakuho种Species山桃P.davidiana山桃P.davidiana甘肃桃P.kansuensis甘肃桃P.kansuensis普通桃P.persica普通桃P.persica普通桃P.persica普通桃P.persica普通桃P.persica普通桃P.persica普通桃P.persica普通桃P.persica普通桃P.persica普通桃P.persica普通桃P.persica普通桃P.persica普通桃P.persica普通桃P.persica普通桃P.persica普通桃P.persica普通桃P.persica普通桃P.persica起源地或育种地Origins or breeding location华北North of China中国辽宁Liaoning,China中国甘肃Gansu,China中国甘肃Gansu,China中国河南Henan,China中国河南Henan,China中国河南Henan,China中国江苏Jiangsu,China中国江苏Jiangsu,China中国河南Henan,China日本Japan中国浙江Zhejiang,China中国江苏Jiangsu,China中国河南Henan,China中国江苏Jiangsu,China中国浙江Zhejiang,China中国浙江Zhejiang,China中国江苏Jiangsu,China中国安徽Anhui,China日本Japan日本Japan日本Japan抗性类型The level of resistance高抗High resistant高抗High resistant高抗High resistant高抗High resistant抗病Resistant抗病Resistant抗病Resistant抗病Resistant抗病Resistant抗病Resistant抗病Resistant感病Susceptible感病Susceptible感病Susceptible感病Susceptible感病Susceptible感病Susceptible感病Susceptible感病Susceptible高感High susceptible高感High susceptible高感High susceptible
供试菌株:桃拟茎点霉(Diaporthe amygdali)由中国农业科学院郑州果树研究所果树病害防控课题提供。
供试药剂15种,分别为95%苯醚甲环唑(Difenoconazole)原药(上海生农生化制品股份有限公司)、98%吡唑醚菌酯(Pyraclostrobin)原药(陕西诺正生物科技有限公司)、95%丙环唑(Propiconazole)原药(山东东泰农化有限公司)、96%啶酰菌胺(Boscalid)原药(浙江禾本科技股份有限公司)、98%多菌灵(Carbendazim)原药(山东潍坊润丰化工股份有限公司)、99%噁霉灵(Hymexazol)原药(青岛星牌作物科学有限公司)、95%氟硅唑(Flusilazole)原药(山东潍坊润丰化工股份有限公司)、95%咯菌腈(Fludioxonil)原药(山东潍坊润丰化工股份有限公司)、95%己唑醇(Hexaconazole)原药(山东潍坊润丰化工股份有限公司)、97%咪鲜胺(Prochloraz)原药(山东华阳农药化工集团有限公司)、98%嘧菌酯(Azoxystrobin)原药(江阴苏利化学股份有限公司)、97%肟菌酯(Trifloxystrobin)原药(山东华阳农药化工集团有限公司)、97%戊唑醇(Tebuconazole)原药(山东潍坊润丰化工股份有限公司)、96%异菌脲(Lprodione)原药(山东潍坊润丰化工股份有限公司)、95%二氰蒽醌(Dithianon)原药(江西禾益化工股份有限公司)。
1.2 杀菌剂毒力测定
15 种杀菌剂对桃枝枯病菌的抑制效果测定。选择15 种杀菌剂(苯醚甲环唑、吡唑醚菌酯、丙环唑、啶酰菌胺、多菌灵、噁霉灵、氟硅唑、咯菌腈、己唑醇、咪鲜胺、嘧菌酯、肟菌酯、戊唑醇、异菌脲、二氰蒽醌)进行室内毒力测定,步骤为:称取各种药剂,用丙酮分别将原药溶解,将溶解后的原药分别用0.1%吐温-80 水溶液配成1%的母液备用。用配好的母液,在预试验的基础上根据需要配置系列质量浓度。噁霉灵的系列终质量浓度为0.25、0.5、1、2、4、8、16 mg·L-1,其他药剂的质量系列终浓度为0.01、0.033、0.1、0.33、1、3 和9 mg·L-1。在无菌操作条件下,配置各药剂的含药PDA 平板。每个处理3 次重复,设置不含药剂的处理作为空白对照。将培养好的桃拟茎点霉菌株接种到各平板的中央,放到26 ℃培养箱中培养。待空白对照长满培养皿时,用数显游标卡尺十字交叉测量各处理的菌落扩展直径。
按公式(1)计算各浓度对病原菌菌丝生长的抑制率。
式中:I为菌丝生长抑制率;DO为空白对照菌落直径;DT为药剂处理菌落直径。
1.3 桃枝条韧皮部样品采集
1.3.1 22 份不接种病原菌韧皮部样品的采集 在王丽等[10]前期的研究中,通过对桃枝枯病1 年生枝条接种桃拟茎点霉后第7 天的病斑长度进行调查,可将37 份桃种质分为4 类,其中高抗、抗、感和高感种质分别有5、11、15 和6 份。选择其中的22 份种质,收集其一年生新梢没有接种病原菌部位的韧皮部组织,液氮速冻后带至实验室,用于挥发性物质含量的测定。不同种质来自同一个果园,栽培管理条件一致,树体大小一致。种质抗性的详细信息见表1。
1.3.2 2份接种病原菌韧皮部样品的采集 同时选择其中的2 个桃品种(奉化蟠桃和白凤),用于接种桃枝枯病菌,接种方法参照王丽等[10]的报道。每个品种每次处理接种10 个点,3 次重复,以空白PDA培养基接种作为对照。接种后每天观察发病情况,在接种7 d后,用游标卡尺测量病斑直径。采集处理后的枝条坏死斑周围的韧皮部组织,用液氮速冻后,用于测定挥发性物质含量。
1.4 枝条韧皮部挥发性物质含量的测定
称取5 g 桃枝条韧皮部材料,液氮研磨后,转移至样品瓶中,加入3mL20% CaCl2 溶液、3mL 200mmol·L-1EDTA溶液,30μL 内标,涡旋混匀。40 ℃平衡30 min后,用65 μm Carboxen∕聚二甲基硅氧烷(PDMS)固相微萃取头萃取30 min后进样。
所用的GC-MS联用仪为美国Agilent公司生产的7890-5975C 型。MS 离子源温度230 ℃,离子化方式为电子轰击电离,电子能量70 eV,四级杆温度为150 ℃,传输线温度为250 ℃;进样口:加热器250 ℃,压力48.954 5 kpa,隔垫吹扫流量3 mL·min-1,进样模式为不分流;色谱柱:30 m DB-WAX(安捷伦),流量1 mL·min-1,压力48.954 5 kpa,恒定流量,后运行1 mL·min-1;柱箱:柱箱温度开启40 ℃,初始值40 ℃保持2 min;以3 ℃·min-1 升至100 ℃,再以5 ℃·min-1升至245 ℃;辅助加热器:开启,250 ℃;时间3 min,扫描起点50,扫描终点550,阈值150,扫描速度1562 u·s-1,溶剂延迟3 min。
1.5 挥发性物质的定量分析
质谱图集采集结束后,在GC-MS 系统打开NIST14.L质谱库,在网站主界面信息检索栏查找相关试验测试数据,以质谱图中的数据作为对比,根据测试数据的匹配度对挥发性物质进行定性分析。
挥发性物质相对含量计算方法为:组分含量(μg·kg-1)=各组分的峰面积/内标的峰面积×内标质量(μg)×1000/样品量(g),内标为仲辛醇。
1.6 数据分析
采用Excel软件对试验数据进行统计分析,根据各药剂浓度对数值及对应的防效概率值作回归分析,计算各药剂的回归方程、相关系数和有效中浓度(EC50)值。
2 结果与分析
2.1 不同药剂对桃枝枯病菌的毒力测定
测定了15种药剂对桃枝枯病菌的毒力,结果表明,15种药剂对桃枝枯病菌均有抑制作用,但EC50值差别比较大,在0.004 2~49.025 2 mg·L-1之间(表2)。其中咪鲜胺的抑制作用最强,其EC50值为0.004 2 mg·L-1;苯醚甲环唑、吡唑醚菌酯、丙环唑、咯菌腈、氟硅唑、己唑醇和戊唑醇对桃枝枯病菌也有较好的抑制作用,EC50值均小于1 mg·L-1;其次为多菌灵、噁霉灵、异菌脲和二氰蒽醌,EC50值在1~10 mg·L-1之间;再次为肟菌酯和嘧菌酯,EC50 值分别为14.379 2 mg·L-1 和25.370 9 mg·L-1;啶酰菌胺对桃枝枯病菌的抑制作用最差,EC50值为49.025 2 mg·L-1。
表2 15 种药剂对桃枝枯病菌的毒力测定
Table 2 The toxicity of fifteen fungicides to D.amygdali

药剂Fungicides咪鲜胺Prochloraz氟硅唑Flusilazole苯醚甲环唑Difenoconazole吡唑醚菌酯Pyraclostrobin戊唑醇Tebuconazole己唑醇Hexaconazole咯菌腈Fludioxonil丙环唑Propiconazole异菌脲Lprodione多菌灵Carbendazim二氰蒽醌Dithianon噁霉灵Hymexazol肟菌酯Trifloxystrobin嘧菌酯Azoxystrobin啶酰菌胺Boscalid毒力回归方程Virulence regression equation Y=7.415 3+1.015 9X Y=6.684 0+1.050 6X Y=6.034 9+0.837 2X Y=5.996 0+0.807 3X Y=6.098 1+1.112 9X Y=5.792 4+1.113 8X Y=5.735 4+1.363 9X Y=5.441 7+1.168 6X Y=4.998 8+1.076 7X Y=4.652 0+0.909 3X Y=4.371 5+0.844 9X Y=2.916 2+2.380 5X Y=4.640 9+0.310 2X Y=4.718 0+1.015 9X Y=4.124 7+0.517 8X相关系数Correlation,r 0.978 4 0.976 5 0.961 6 0.955 3 0.965 8 0.966 1 0.976 0 0.957 1 0.951 6 0.964 6 0.953 2 0.962 2 0.924 4 0.986 4 0.969 4有效中浓度EC50/(mg·L-1)0.004 2 0.025 0 0.057 2 0.058 4 0.103 1 0.194 3 0.288 9 0.444 3 1.002 6 2.413 6 5.544 8 7.505 1 14.379 2 25.370 9 49.025 2 EC50置信限EC50Confidence limit 0.001 8~0.009 9 0.014 6~0.042 7 0.030 4~0.107 6 0.025 8~0.132 1 0.062 9~0.169 1 0.116 6~0.323 8 0.192 7~0.433 2 0.241 8~0.816 6 0.487 5~2.062 3 1.143 0~5.096 7 2.067 0~14.873 7 5.167 2~10.900 9 2.282 1~90.600 5 12.322 7~52.235 6 14.330 0~167.722 9
部分药剂的防治效果如图1所示,咪鲜胺、氟硅唑、苯醚甲环唑为抑制效果较好的3 个药剂;肟菌酯、嘧菌酯和啶酰菌胺为抑制效果较差的3个药剂。
图1 药剂对桃枝枯病菌的室内毒力测试
Fig.1 In vitro experimental results of fungicides against D.amygdali
2.2 22 份不同抗性桃种质韧皮部的挥发性物质含量分析
利用顶空固相微萃取-气质谱联用技术对22份桃种质(表1)进行挥发性物质含量测定,供试样品可以检测出121种挥发性物质。这些物质可以分为12 类:萜烯类30 种,酯类22 种,醇类17 种,酮类16种,醛类13种,烷烃类5种,脂肪酸类4种,酚类3种,呋喃类3种,酸类2种,内酯类1种,其他类5种。从单个样品的挥发性物质个数上看,日川白凤和红甘露的挥发性物质种类最多,分别为85种和80种;白花和帚形山桃挥发性物质种类最少,分别为52和51种。
供试22份桃种质的总挥发性物质含量(w)范围为46449.55~581121.78μg·kg-1,平均为279726.80μg·kg-1;总挥发性物质含量较低的3 份样品为帚形山桃、白凤和湖景蜜露,含量分别为66 229.10、66 116.43和46 449.55 μg·kg-1;挥发性物质含量较高的3 份样品为雨花露、红甘露和中油蟠7 号,含量分别为420 383.33、425 214.70和581 121.78 μg·kg-1。
2.3 桃拟茎点霉菌抗性与其挥发性物质组分的相关性分析
为鉴定与抗桃拟茎点霉菌相关的挥发性物质,对22 份桃种质的挥发性物质含量与该种质对桃拟茎点霉菌的抗性进行了相关性分析。发现有16 种挥发性物质与抗性呈显著负相关,6 种挥发性物质与抗性呈显著正相关。在显著负相关物质中,包括1种酸、1种醛、2种烷烃、2种酯、1种脂肪酸、4种酮、1种酚和4种萜烯类物质,负相关系数最高的为酯类物质油酸二十烷醇酯,达到了-0.676 5(P<0.01)。显著正相关的物质包括1 种醇、2 种醛、1 种酯、1 种酮和1 种萜烯类物质,其中正相关系数最高的为醛类物质2-庚烯醛,达到了0.570 4(P<0.01)。
选择其中两种物质正十六烷和1-壬醇,分析其含量与抗桃拟茎点霉菌活性的相关关系,如图2 所示。其中,正十六烷在高感种质中的含量显著高于其他抗性种质;而高抗种质中的1-壬醇含量高于感病种质,但与抗病、高感种质的含量没有差异。

图2 对桃拟茎点霉抗性不同的22 份种质的2 种挥发性物质含量的分布
Fig.2 The distribution of contents of two volatile compounds with different resistance level to D.amygdali of 22 germplasms
A.正十六烷的含量分布;B.1-壬醇的含量分布;*表示在P<0.05 水平上差异显著。
A.The distribution of contents of n-Hexadecane;B.The distribution of contents of 1-Nonanol;*indicates significant difference at P<0.05.
2.4 桃枝枯病菌诱导桃枝条韧皮部的挥发性物质含量变化分析
为再次验证挥发性物质含量与枝枯病抗性之间的关系,选择对拟茎点霉抗性不同的2 个桃品种接种病原菌。接种7 d后观察发现,奉化蟠桃和白凤的病斑直径分别为52.62 mm和84.50 mm(图3-A)。

图3 2 个桃品种接种拟茎点霉菌后的病斑大小(A)以及与抗性正(B)和负(C)相关的物质含量变化
Fig.3 Changes in lesion size(A)and their compound contents related to positive(B)and negative(C)resistance of two peach varieties inoculated with D.amygdali
不同小写字母表示差异显著(P<0.05)。
Different small letters indicate significant differences(P<0.05).
同时,对上述2 个样品病斑周围的韧皮部组织进行挥发性物质含量测定,发现在接种病原菌后,与抗性呈正相关的挥发性物质2-庚烯醛含量在感病品种奉化蟠桃中快速上升,而在高感品种白凤中上升幅度较小(图3-B),表明2-庚烯醛含量的上升可能增强了品种的抗性。而与抗性呈负相关的挥发性物质苯甲酸含量在2 个品种中都受到诱导,但在感病品种中上升的幅度低于高感品种(图3-C),暗示该物质含量的上升降低了品种的抗性。
3 讨 论
桃是中国重要的鲜食水果树种,但枝枯病的发生严重影响了中国桃产业的可持续发展。目前,化学防治是防治桃枝枯病的主要方法,但长期不合理地使用化学药剂会导致防效不理想,而加大农药使用量则会造成农药超标、病原菌产生抗药性等问题。笔者通过对15 种药剂进行毒力测试,证实咪鲜胺对桃枝枯病菌的抑菌活性较强(EC50 值为0.004 2 mg·L-1),与纪兆林等[16]的报道高度一致(EC50值为0.004 7 mg·L-1),这为其田间应用提供了强有力的支持;而多菌灵EC50值为2.413 6 mg·L-1,高于纪兆林等[16]的结果(EC50值为0.027 6 mg·L-1)。这种差异可能与病原菌群体对多菌灵抗药性发展有关,在防治中需关注抗性风险并轮换用药。虽然肟菌酯、嘧菌酯和啶酰菌胺属较新型的药剂,但其对桃枝枯病菌的抑制效果不如咪鲜胺及三唑类药剂,并非防治桃枝枯病的首选药剂。但这些药剂杀菌谱广,在防治果园的其他病害中仍有价值,如葡萄白粉病、灰霉病和腐烂病等,尤其啶酰菌胺对灰葡萄孢菌(Botrytis cinerea)引起的灰霉病抑制效果最佳[17]。
植物中的VOCs可以有效地抑制多种植物病原菌的生长和繁殖,或者直接诱导植物的防御系统来抵御病原菌的侵害[18]。对于VOCs的抑菌作用已有大量研究。如Arroyo 等[19]发现反式-2-己烯醛是对草莓炭疽病菌丝生长抑制效果最好的一种VOCs。Guo等[20]研究表明,经反式-2-己烯醛处理后,番茄果实灰霉病的发病率显著降低。香百里香酚和香芹酚在125 mg·L-1时可完全抑制灰霉病[21]。然而VOCs与桃枝枯病抗性的相关性研究报道较少,笔者首次发现桃枝条韧皮部VOCs 中16 种挥发性物质含量与抗性呈显著负相关,6 种挥发性物质含量与抗性呈显著正相关,并鉴定出负相关系数最高的为油酸二十烷醇酯,正相关系数最高的为2-庚烯醛。高含量的负相关物质可能是感病性的标志,其可能竞争性地消耗了用于合成抗病相关化合物的共同前体,也可能干扰防御信号或利于病原菌定殖。枝条在接种拟茎点霉菌后,苯甲酸(负相关物质)在高感品种白凤中的积累量高于感病品种奉化蟠桃,验证了其在干扰防御或利于病原菌侵染方面的作用。而正相关物质的高含量与抗病性紧密关联(如壬醛、1-壬醇、乙酸乙酯和2-庚烯醛),其防御机制可能是具有直接的抑菌活性,而在前人研究中,2-庚烯醛和1-壬醇曾被报道与黄曲霉(Aspergillus flavus)的生长相关[22-23],而壬醛和乙酸乙酯则分别与抗白色念珠菌(Candida albicans)和大丽轮枝菌(Verticillium dahliae)相关[24-25]。此外,正相关物质也可能起到防御反应诱导子的作用,或作为挥发信号介导间接防御。枝条在接种拟茎点霉后,2-庚烯醛含量在奉化蟠桃中上升速度快于白凤,验证了其作为主动防御响应的重要组成部分的结论。
4 结 论
在15种药剂中,咪鲜胺对桃枝枯病菌的抑制作用最强,可为筛选适宜的化学防控药品提供依据。同时,16 种挥发性物质含量与抗性呈显著负相关,负相关系数最高的为酯类物质油酸二十烷醇酯;6种挥发性物质含量与抗性呈显著正相关,正相关系数最高的为醛类物质2-庚烯醛。本研究为未来开发新型生物防治制剂以及基于挥发物谱辅助筛选或创制高抗枝枯病的抗性桃品种奠定了重要的理论基础,为最终实现桃枝枯病的可持续综合防治提供了新思路和新方法。
[1] 宋长年,徐康,董瑞萍,李广勇,陆明莹,银海玲,周哲.桃病害防治技术研究进展[J].安徽农业科学,2021,49(22):33-35.SONG Changnian,XU Kang,DONG Ruiping,LI Guangyong,LU Mingying,YIN Hailing,ZHOU Zhe. Research progress on peach disease control technology[J]. Journal of Anhui Agricultural Sciences,2021,49(22):33-35.
[2] DAI F M,ZENG R,LU J P.First report of twig canker on peach caused by Phomopsis amygdali in China[J]. Plant Disease,2012,96(2):288.
[3] DELACROIX G. Surune maladie des amandiers en Provence[J].Bulletin Trimestriel de la Société Mycologique de France,1905,21(3):180-185.
[4] LALANCETTE N,POLK D F. Estimating yield and economic loss from constriction canker of peach[J]. Plant Disease,2000,84(9):941-946.
[5] FARR D F,CASTLEBURY L A,PARDO-SCHULTHEISS R A.Phomopsis amygdali causes peach shoot blight of cultivated peach trees in the southeastern United States[J]. Mycologia,1999,91(6):1008-1015.
[6] 严东辉. 桃树溃疡病侵染循环的研究[J]. 西南林学院学报,1989,9(2):153-161.YAN Donghui. The infection cycle of peach canker[J]. Journal of Southwest Forestry College,1989,9(2):153-161.
[7] 纪兆林,戴慧俊,金唯新,宋宏峰,童蕴慧,徐敬友.桃枝枯病发生规律研究[J].中国果树,2016(2):13-17.JI Zhaolin,DAI Huijun,JIN Weixin,SONG Hongfeng,TONG Yunhui,XU Jingyou. Study on the occurrence law of peach branch blight[J].China Fruits,2016(2):13-17.
[8] TUSET J J,PORTILLA M A T. Taxonomic status of Fusicoccum amygdali and Phomopsis amygdalina[J]. Canadian Journal of Botany,1989,67(5):1275-1280.
[9] FROELICH M H,SCHNABEL G. Investigation of fungi causing twig blight diseases on peach trees in south Carolina[J].Plant Disease,2019,103(4):705-710.
[10] 王丽,涂洪涛,侯珲,周贝贝,孟帅,堵墨.桃枝枯病病原菌鉴定及品种(种质)室内抗病性评价[J].果树学报,2024,41(5):980-989.WANG Li,TU Hongtao,HOU Hui,ZHOU Beibei,MENG Shuai,DU Mo. Identification of the pathogen of peach shoot blight and indoor resistance evaluation of peach varieties(germplasms)[J].Journal of Fruit Science,2024,41(5):980-989.
[11] UDDIN W,STEVENSON K L. Seasonal development of Phomopsis shoot blight of peach and effects of selective pruning and shoot debris management on disease incidence[J].Plant Disease,1998,82(5):565-568.
[12] 纪兆林,汪孝璊,王汝艳,董京萍,徐敬友,童蕴慧,金唯新,宋宏峰.多效唑对桃枝枯病的调控作用研究[J].扬州大学学报(农业与生命科学版),2017,38(4):99-104.JI Zhaolin,WANG Xiaomen,WANG Ruyan,DONG Jingping,XU Jingyou,TONG Yunhui,JIN Weixin,SONG Hongfeng. Effect of paclobutrazol on control of peach shoot blight[J].Journal of Yangzhou University(Agricultural and Life Science Edition),2017,38(4):99-104.
[13] 范昆,付丽,张义坤,武海斌,孙瑞红,曲健禄.丁香菌酯与辛菌胺混配对桃枝枯病的防治研究[J].落叶果树,2021,53(1):49-52.FAN Kun,FU Li,ZHANG Yikun,WU Haibin,SUN Ruihong,QU Jianlu. Study on the prevention and control of peach shoot blight disease by mixing syringin and octanil[J]. Deciduous Fruits,2021,53(1):49-52.
[14] MUN H,TOWNLEY H E. Nanoencapsulation of plant volatile organic compounds to improve their biological activities[J].Planta Medica,2021,87(3):236-251.
[15] 李志昊.挥发性有机化合物对桃果实采后真菌病害的控制及感官品质的影响[D].杭州:浙江大学,2023.LI Zhihao. Control of postharvest disease and changes in sensory quality of peach fruit by volatile organic compounds[D].Hangzhou:Zhejiang University,2023.
[16] 纪兆林,戴慧俊,张慧琴,金建芳,熊彩珍,徐敬友.不同杀菌剂对桃枝枯病菌的毒力和田间防效[J].果树学报,2013,30(2):281-284.JI Zhaolin,DAI Huijun,ZHANG Huiqin,JIN Jianfang,XIONG Caizhen,XU Jingyou. Virulence and control efficacy in field of fungicides on Phomopsis amygdali of peach[J]. Journal of Fruit Science,2013,30(2):281-284.
[17] TOMITSUKA E,HIRAWAKE H,GOTO Y,TANIWAKI M,HARADA S,KITA K. Direct evidence for two distinct forms of the flavoprotein subunit of human mitochondrial complex Ⅱ(succinate-ubiquinone reductase)[J]. The Journal of Biochemistry,2003,134(2):191-195.
[18] UL HASSAN M N,ZAINAL Z,ISMAIL I.Green leaf volatiles:Biosynthesis,biological functions and their applications in biotechnology[J].Plant Biotechnology Journal,2015,13(6):727-739.
[19] ARROYO F T,MORENO J,DAZA P,BOIANOVA L,ROMERO F.Antifungal activity of strawberry fruit volatile compounds against Colletotrichum acutatum[J]. Journal of Agricultural and Food Chemistry,2007,55(14):5701-5707.
[20] GUO M R,FENG J Z,ZHANG P Y,JIA L Y,CHEN K S.Postharvest treatment with trans- 2- hexenal induced resistance against Botrytis cinerea in tomato fruit[J].Australasian Plant Pathology,2015,44(1):121-128.
[21] ZHAO Y,YANG Y H,YE M,WANG K B,FAN L M,SU F W.Chemical composition and antifungal activity of essential oil from Origanum vulgare against Botrytis cinerea[J].Food Chemistry,2021,365:130506.
[22] DUAN W Y,ZHANG S B,LÜ Y Y,ZHAI H C,WEI S,MA P G,CAI J P,HU Y S. Inhibitory effect of (E)-2-heptenal on Aspergillus flavus growth revealed by metabolomics and biochemical analyses[J].Applied Microbiology and Biotechnology,2023,107(1):341-354.
[23] QIN Y L,ZHANG S B,LV Y Y,ZHAI H C,HU Y S,CAI J P.Transcriptomics analyses and biochemical characterization of Aspergillus flavus spores exposed to 1-nonanol[J].Applied Microbiology and Biotechnology,2022,106(5):2091-2106.
[24] CHOUGULE S A,GAVANDI T C,PATIL S B,BASRANI S T,SAWANT D,YANKANCHI S R,JADHAV A K,KARUPPAYIL S M.Nonanal inhibits growth and virulence factors in Candida albicans[J]. Pharmacological Research- Natural Products,2025,7:100256.
[25] WANG Y H,LI J X,CHEN Q H,ZHOU J,XU J W,ZHAO T T,HUANG B S,MIAO Y H,LIU D H. The role of antifungal activity of ethyl acetate extract from Artemisia argyi on Verticillium dahlia[J]. Journal of Applied Microbiology,2022,132(2):1343-1356.